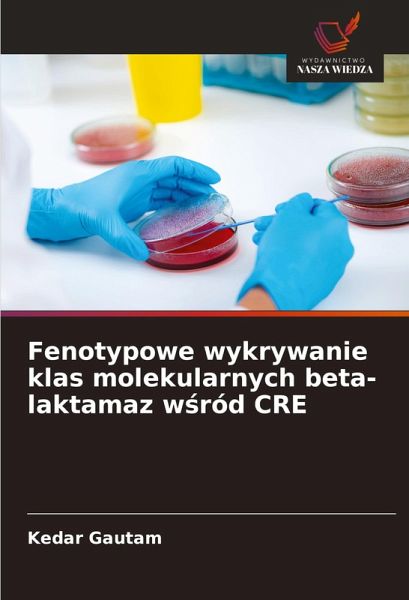

Fenotypowe wykrywanie klas molekularnych beta-laktamaz w¿ród CRE
Versandkostenfrei!
Versandfertig in 6-10 Tagen
39,99 €
inkl. MwSt.
PAYBACK Punkte
20 °P sammeln!
Niniejsza ksi¿¿ka jest prac¿ przeprowadzon¿ w Szpitalu Dzieci¿cym Kanti w Katmandu w celu okre¿lenia obci¿¿enia izolatami Enterobacteriaceae opornymi na karbapenem, wytwarzaj¿cymi ró¿ne typy ß-laktamaz. Zaobserwowano, ¿e w¿ród Enterobacteriaceae pojawi¿y si¿ wszystkie klasy karbapenemaz. Poniewä stwierdzono du¿¿ zmienno¿¿ ß-laktamaz CRE, aby zmniejszy¿ ryzyko powänej katastrofy, skuteczne procedury wykrywania s¿ obowi¿zkowe we wszystkich laboratoriach klinicznych.